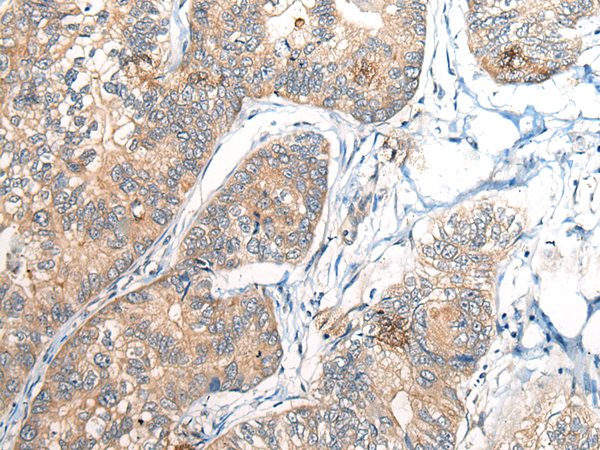

中文名稱:兔抗BCAN多克隆抗體
|
Background: |
This gene encodes a member of the lectican family of chondroitin sulfate proteoglycans that is specifically expressed in the central nervous system. This protein is developmentally regulated and may function in the formation of the brain extracellular matrix. This protein is highly expressed in gliomas and may promote the growth and cell motility of brain tumor cells. Alternate splicing results in multiple transcript variants. |
|
Applications: |
ELISA, IHC |
|
Name of antibody: |
BCAN |
|
Immunogen: |
Fusion protein of human BCAN |
|
Full name: |
brevican |
|
Synonyms: |
BEHAB; CSPG7 |
|
SwissProt: |
Q96GW7 |
|
ELISA Recommended dilution: |
5000-10000 |
|
IHC positive control: |
Human thyroid cancer and human gastric cancer |
|
IHC Recommend dilution: |
30-150 |

購物車
幫助
021-54845833/15800441009
